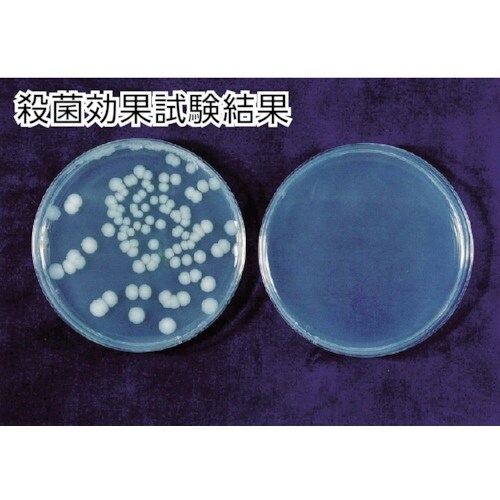
エレクトロン エアータオル KTM−100
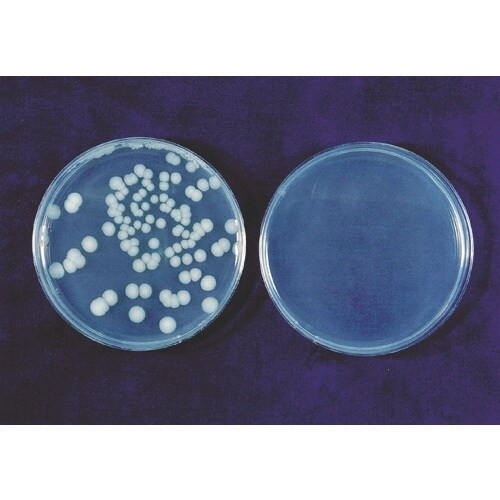
エレクトロン エアータオル KTM−100

消毒・除菌・感染予防用品(その他)の売れ筋ランキング
- ¥768(税込) (税込) 〜
- ¥8,474(税込) (税込)
- ¥4,125(税込) (税込)
- ¥2,057(税込) (税込)
- ¥8,311(税込) (税込)
- ¥364(税込) (税込)
- ¥543(税込) (税込)
商品の特徴 |
ハイパワー温風(風速120m/s)でスピード乾燥ができます。全て抗菌樹脂仕様で衛生的です。上下分別設計ですので狭いスペースにも設置が可能です。無電圧A接(自動扉連動仕様)です。手指乾燥。 |
|---|---|
商品仕様 |
|
メーカー情報 |
|
カタログ掲載ページ |
-/- |
| 注意事項 | ※コンクリート、タイル以外の壁面に取り付ける場合は、壁面の素材に合ったアンカーが必要です。 |
|---|